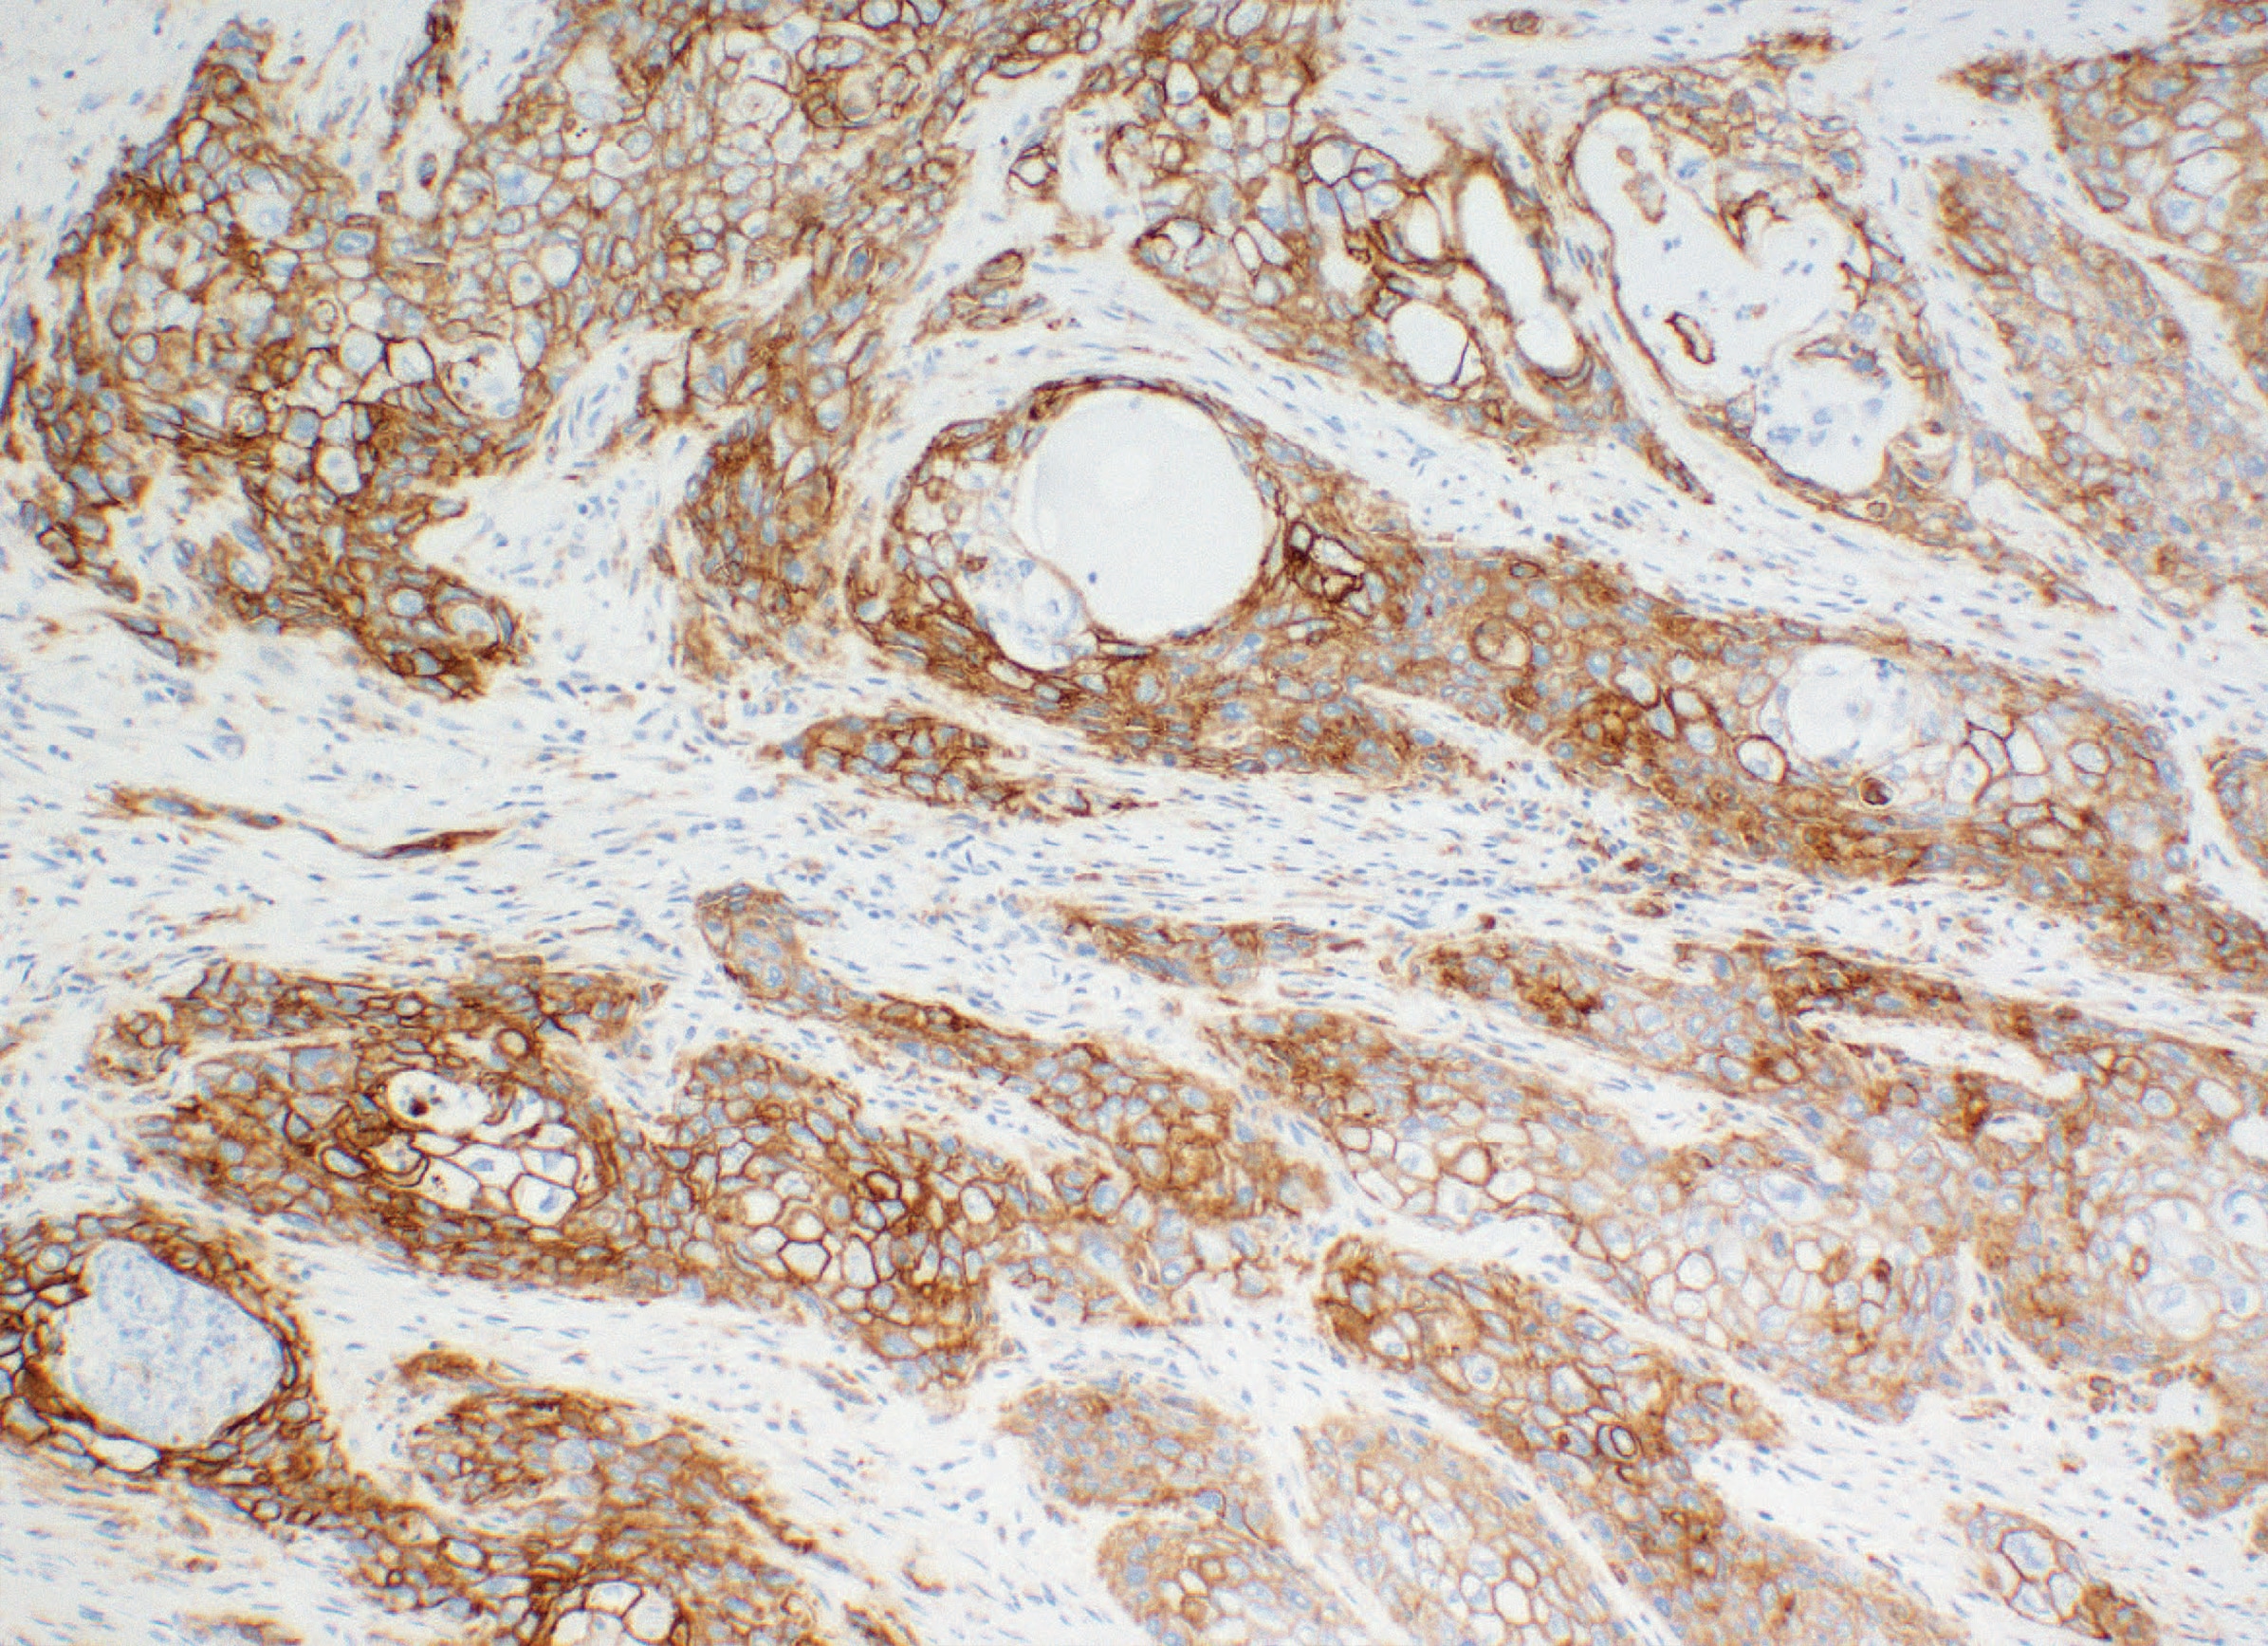

PD-L1 IHC 28-8 pharmDx Interpretation Training


head-and-neck (SCCHN), urothelial carcinoma (UC) including, muscle invasive urothelial carcinoma (MIUC), melanoma, gastric adenocarcinoma, gastroesophageal junction (GEJ) adenocarcinoma, esophageal adenocarcinoma, and esophageal squamous cell carcinoma (ESCC)
The PD-L1 IHC 28-8 pharmDx interpretation training is a comprehensive program with in-depth content and practice cases focused on helping pathologists to:
- Understand the role of immune checkpoint pathways
- Learn about technical considerations for optimal slide staining results
- Learn how to evaluate nsNSCLC, SCCHN, UC (including MIUC), melanoma, gastric adenocarcinoma, GEJ adenocarcinoma, esophageal adenocarcinoma, and ESCC specimens stained with PD-L1 IHC 28-8 pharmDx
Enhanced nsNSCLC, SCCHN, UC (including MIUC), melanoma, gastric adenocarcinoma, GEJ adenocarcinoma, esophageal adenocarcinoma, and ESCC training programs with a virtual microscope for increased confidence in scoring PD-L1 stained slides.
Intended Use
For in vitro diagnostic use.
PD-L1 IHC 28-8 pharmDx is a qualitative immunohistochemical assay using Monoclonal Rabbit Anti-PD-L1, Clone 28-8 intended for use in the detection of PD-L1 protein in formalin-fixed, paraffin-embedded (FFPE) non-squamous non-small cell lung cancer (nsNSCLC), squamous cell carcinoma of the head and neck (SCCHN), urothelial carcinoma (UC), melanoma, gastric adenocarcinoma, gastroesophageal junction (GEJ) adenocarcinoma, and esophageal carcinoma tissues using EnVision FLEX visualization system on Autostainer Link 48.
PD-L1 protein expression in nsNSCLC, SCCHN, UC, muscle invasive urothelial carcinoma (MIUC), melanoma, and esophageal squamous cell carcinoma (ESCC) is determined by using % tumor cell expression, which is the percentage of evaluable tumor cells exhibiting partial or complete membrane staining at any intensity.
PD-L1 protein expression in gastric adenocarcinoma, GEJ adenocarcinoma, and esophageal adenocarcinoma is determined by using Combined Positive Score (CPS), which is the number of PD-L1 staining cells (tumor cells, lymphocytes, macrophages) divided by the total number of viable tumor cells, multiplied by 100.
Companion Diagnostic Indications
|
Tumor Indication |
PD-L1 Expression Clinical |
Intended Use |
|
MIUC |
≥ 1% tumor cell expression |
PD-L1 IHC 28-8 pharmDx is indicated as an aid in identifying MIUC patients for treatment with OPDIVO® (nivolumab). |
|
ESCC |
≥ 1% tumor cell expression |
PD-L1 IHC 28-8 pharmDx is indicated as an aid in identifying ESCC patients for treatment with OPDIVO® (nivolumab) in combination with fluoropyrimidine and platinum-based chemotherapy or OPDIVO® (nivolumab) in combination with YERVOY® (ipilimumab). |
|
Gastric, GEJ, or Esophageal Adenocarcinoma |
CPS ≥ 5 |
PD-L1 IHC 28-8 pharmDx is indicated as an aid in identifying gastric, gastroesophageal junction, or esophageal adenocarcinoma patients for treatment with OPDIVO® (nivolumab) in combination with fluoropyrimidine and platinum-based chemotherapy. |
PD-L1 expression (≥ 1% or ≥ 5% or ≥ 10% tumor cell expression) as detected by PD-L1 IHC 28-8 pharmDx in non-squamous NSCLC (nsNSCLC) may be associated with enhanced survival from OPDIVO® (nivolumab).
PD-L1 expression (≥ 1% tumor cell expression) as detected by PD-L1 IHC 28-8 pharmDx in SCCHN may be associated with enhanced survival from OPDIVO® (nivolumab).
PD-L1 expression (≥ 1% tumor cell expression) as detected by PD-L1 IHC 28-8 pharmDx in urothelial carcinoma may be associated with enhanced response rate from OPDIVO® (nivolumab).
PD-L1 expression (≥ 1% or ≥ 5% tumor cell expression) as detected by PD-L1 IHC 28-8 pharmDx in melanoma may be used as an aid in the assessment of patients for whom OPDIVO® (nivolumab) and YERVOY® (ipilimumab) combination treatment is being considered.
See the local OPDIVO® and YERVOY® product labels for specific clinical circumstances guiding PD-L1 testing.
D70798